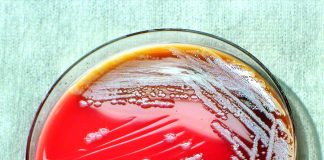
Agentii patogeni – inamicii sanatatii Agentii patogeni - inamicii sanatatii

Aparatul dentar
Un zambet frumos, dinti sanatosi, bine aliniati, care pot fi ingrijiti mai usor, toate acestea se pot realiza cu ajutorul unui aparat dentar, la...
Boala celiaca – Intoleranta la gluten
Boala celiaca reprezinta intoleranta si sensibilitatea intestinului subtire la gluten si este considerata ca fiind una dintre cele mai raspandite boli genetice din Europa....
Agentii patogeni – inamicii sanatatii
Agentii patogeni (virusuri, microbi, paraziti) sunt prezenti in mediul inconjurator permanent si sunt responsabili de aparitia bolilor infectioase. Solul contine milioane de bacterii pe...
Ce este aparatul auditiv si cum se poate procura?
Aparatul auditiv este o solutie eficace, pe care o ofera tehnologia moderna celor care, din diverse motive, sufera de o deficienta de auz, care...
Infectia cu Chlamydia
Clamidioza este o boala infectioasa bacteriana care este produsa de agentul Chlamydia – provocat de Chlamydia trachomatis – un microorganism care ar putea fi...
Metode de tratament in cazul infectiei cu Chlamydia trachomatis
In cazul unei infectii cu Chlamydia trachomatis medicul de specialitate va prescrie cu siguranta un tratament cu medicamente antibiotice pentru inlaturarea infectiei. Persoanelor aflate...
Boala inflamatorie pelviana – Simptome, cauze si tratament
Boala inflamatorie pelviana reprezinta infectia unui organ pelvian feminin, in special a uterului, trompelor uterine si a ovarelor.In ultimii ani, aceasta boala a devenit...
Vezi care sunt cele mai simple remedii pentru indepartarea bataturilor
Bataturile sunt formatiuni cornoase ale epidermei de culoare brun-galbuie, care apar in punctele de presiune ale incaltamintei si care sunt foarte neatractive si dureroase...
Cancerul mamar – Tratamente naturiste
Apare sub forma unui nodul dur si de forma neregulata, in san. De multe ori apar mancarimi si secretii. Nu intotdeuna un nodul este...
Tratamente naturiste pentru hipertensiunea arteriala
Hipertensiunea arteriala consta in cresterea accidentala sau permanenta a presiunii de curgere a sangelui din ventriculul stang spre sistemul venos si arterial. Aceasta afectiune...
Alcoolismul – Simptome, cauze si tratament
Alcoolismul este o boala care se caracterizeaza prin necontenita dorinta de a bea alcool, toleranta si dependenta fata de alcool, precum si pierdera controlului fata...
Tratamente naturiste pentru conjunctivita
Conjunctivita este una din cele mai intalnite infectii oculare. Se caracterizeaza printr-o inflamatie a mucoasei conjunctivale care acopera partea interna a pleoapelor, apoi se...
Cancerul vezicii urinare
Vezica urinara se afla de-a lungul tractului urinar, in ea este depozitata urina produsa de rinichi. Ea este captusita cu un epiteliu tranzitional, care...
Coloana dureroasa
La nivelul coloanei vertebrale sunt o serie de muschi si nervi, care in momentul cand sunt iritati dau dureri de coloana. Acest simptom –...
Ce este congestia sau reactiile congestive si care sunt cauzele lor?
Sunt cunoscute diferite boli si afectiuni care determina reactii congestive, modificari circulatorii in anumite zone: faringe, mucoasa nazala, bronhii, trahee, alveole si altele.Gripa creeaza...